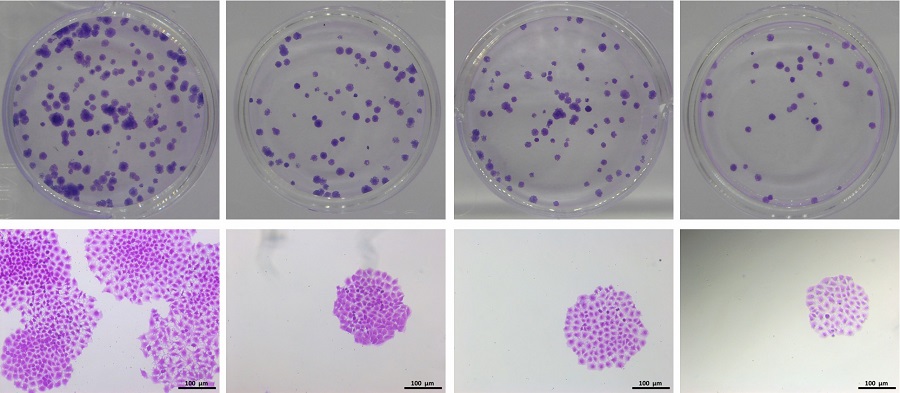

一、服務簡介
單個細胞在體外增殖六代以上,其后代所組成的細胞群體,成為集落或克隆。每個克隆含有50以上的細胞,大小在0.3-1.0 mm之間。集落形成率表示細胞的獨立生存能力。各種理化因素可能導致細胞的克隆形成能力發生改變。克隆形成率反映細胞群體依賴性和增殖能力兩個重要性狀。實驗方法包括平板克隆形成實驗和軟瓊脂克隆形成實驗。
二、技術流程
平板克隆形成實驗:適用于貼壁生長的細胞
1、取對數生長期的各組細胞,制備細胞懸液;
2、將細胞懸液作梯度倍數稀釋,分別接種含培養液的皿中,培養2-3周;
3、經常觀察,當培養皿中出現肉眼可見的克隆時,終止培養;
4、棄去上清液,4%多聚甲醛固定,GIMSA染色液染10-30 min;
5、計算克隆形成率,克隆形成率 =(克隆數/接種細胞數)× 100%;
6、結果統計分析
軟瓊脂克隆形成實驗:適用于非錨著依賴性生長的細胞。
1、制備細胞懸液,梯度倍數稀釋;
2、分別制備1.2%和0.7%瓊脂糖溶液;
3、下層瓊脂凝固后放入37℃培養箱備用;
4、加入細胞懸液,待上層瓊脂凝固后,培養10-14天;
5、計算克隆形成率,克隆形成率 =(克隆數/接種細胞數)× 100%;
6、結果統計分析
三、服務說明 1、檢測細胞株(若實驗室有,可免費提供)。
2、待測毒性藥物(根據實驗方案有無)。
3、實驗設計方案或參考文獻。
4. 若另有疑問歡迎向本公司咨詢,我們將竭誠為您服務。
四、成果展示
五、詢價及訂購
感謝您選擇我公司的細胞克隆形成服務。如有相關問題請聯系我們的工作人員。